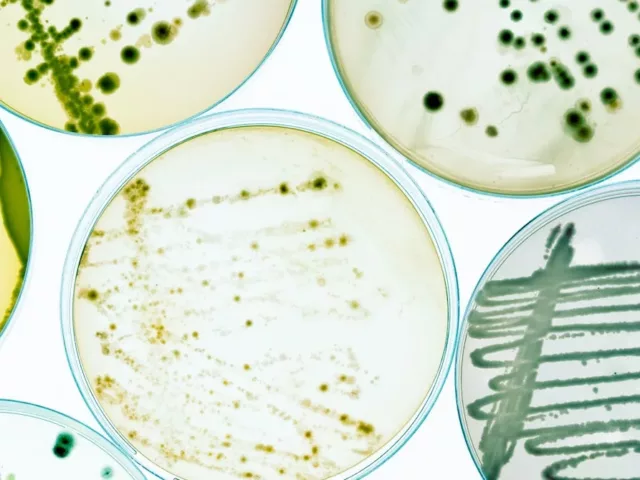
bacteria in petri dish

Digestion
Do Probiotics Help with Bloating? Gut Health Pros Explain.
If you deal with bloating, you’re probably keen to know how to get rid of bloating fast. But do probiotics help with bloating? We took a look at the science. Ugh, bloating. There is nothing pleasant about feeling like there’s an unpopped balloon in your stomach, and it’s not exactly a sign of something particularly […]